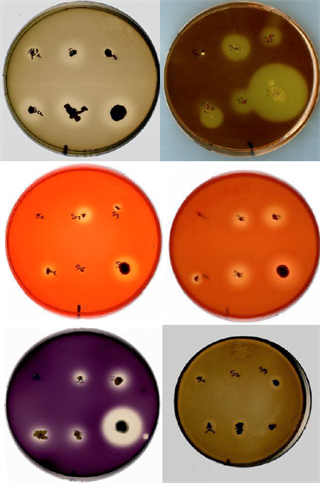

«Nuestros objetivos fueron estudiar la microflora bacteriana asociada a
los fenómenos religiosos, idear estrategias de monitorización ambiental y
de salud, y buscar aplicaciones biotecnológicas».
Realizado por:
- Laura Sánchez Gómez
- Fátima Rodríguez Pacheco
2º de bachillerato del IES Francisco de Orellana
(Trujillo, Cáceres)
Coordinado por Ricardo D. Basco López de Lerma
Premiado 2011